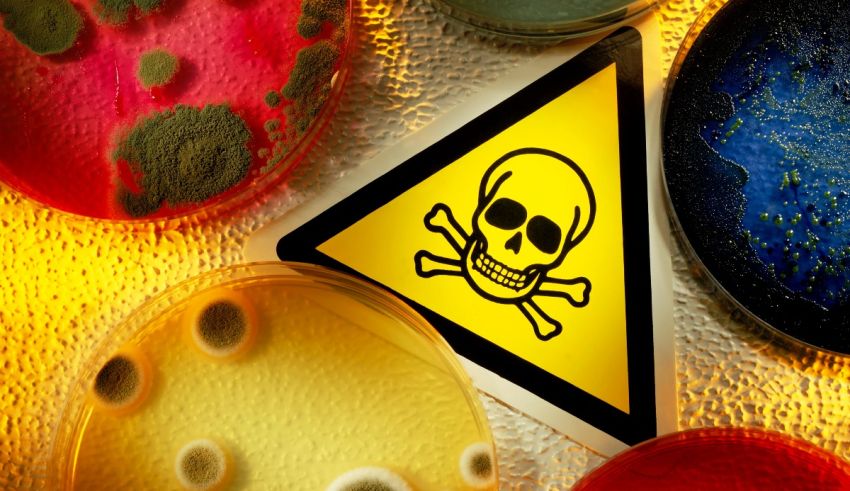
A sign with a skull and crossbones on it.

The Moon Soulmate Test Explained
Comprised of 20 personality, relationship, and romance questions, the Moon Soulmate Test is a love compatibility quiz. It determines if you and your partner have similar, matching, or opposite moon phases and reveals how this might affect your love life.
The moon phases, much like moon signs, are thought to offer insight into personal aspects such as love language, dating personality, and attraction levels towards a partner.
According to a theory, people with complementary moon phases may be soulmates. For example, if one person was born during a Waxing Crescent phase and their partner was born during a Waning Crescent phase, their love is believed to be strong.
What Was the TikTok’s Moon Soulmate Trend About?
In 2023, TikTok users started posting their birth months’ moon phases next to their partners’, showing how compatible they are in terms of astrology and metaphysics. This whole trend then led to the Moon Soulmate Tests, which revealed the same information by analyzing two lovers’ personalities.
If you’re interested in trending TT quizzes, we would also recommend you take are Love Color Quiz which shows what hue your romance is.
How to Find Your Moon Phase Soulmate Match
One way to identify your moon soulmate is by using an online moon phase detector tool. These tools estimate the shape of the moon according to your birthdate and show you a picture of it.
But if that sounds like too much work, use the following table to see if you and your partner are actual twin flames—or soulmates, if you will.
You can also take our Moon Soulmate Test, which is currently the most accurate way of exposing your attraction level to your significant other.
| Moon Phase Match | Likeliest Months | Moderate Months | Least Likely Months |
| Perfect Match | January, February, March, April, May, June, July, August, September, November, December | October | N/A |
| Complementary Match | January, March, May, July, September, November | February, April, June, August, October, December | N/A |
| Challenging Match | February, April, June, August, October, December | January, March, May, July, September, November | N/A |
| Neutral Match | N/A | N/A | January, February, March, April, May, June, July, August, September, October, November, December |
Perfect Moon Phase Match
A perfect match occurs between two individuals with opposite birthdates. This means that the two halves of the moon from each person combine to form a complete moon, symbolizing a divine connection and true love.
Complementary Moon Phase Match
A complementary moon phase may not be an exact match, but it comes close enough to convey a positive connection. This happens when one person’s birth moon largely overlaps with their partner’s shadowed moon.
Challenging Moon Phase Match
In astrology, having a challenging moon phase refers to the idea of being in love with an incompatible person with a moon shape that covers no shadowed parts of your moon sign. This means that you are in love with the wrong person, and you might not be happy in your relationship.
Neutral Moon Phase Match
A neutral moon phase match is when people with two irrelevant shadowed moons fall in love with each other. While such people’s compatibility is low, their relationship’s success mostly depends on how they treat each other and how much they grow together in time.
Does It Even Matter to Know Your Moon Soulmate?
Love is beyond astrology and set rules. Whether your partner’s moon phase matches yours or not, it’s the effort you put into your love that determines whether or not it will last. So, don’t overthink the test results; just do it for fun.
It’s always cute to know that your relationship is a love written in the stars. But don’t forget that the healthiest type of love is the one that’s rooted on the earth and is as humanly as it gets. 🙂❤
Discover Your Astrological Better Half with a Genuine Test
Okay, you’re now ready to figure out if your significant other is actually your moon phase soulmate. All there’s left for you to do is answer 20 relatable questions with honesty to receive instant, accurate results.
Let’s look at the sky and see if you two are moonstruck lovers. 🌓
Also, here’s a little secret: Take our Soulmate Romance Quiz next to see if your partner is actually a romantic person or not. 🤫